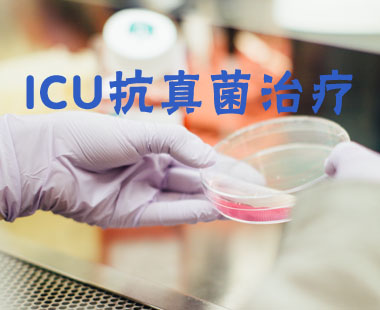

刘永飞,火箭军总医院重症医学科。
课时数
课程播放数

主讲:刘永飞 课时:1 发布时间:2019/06/04
简介: 本课程是由火箭军总医院重症医学科的刘永飞主讲,包括五个方面的内容,第一讲述了血气分析的作用:它有两个作用:判断呼吸功能和判断酸碱平衡紊乱。第二常用血气分析指标及临床意义:包括血氧指标,酸碱平衡指标及其它指标。第三酸碱平衡的调节:它包括血液缓冲系统,肺的调节,肾的调节,组织细胞的调节等。第四酸碱平衡紊乱的判读。第五如何减少血气分析前的误差。

主讲:刘永飞 课时:2 发布时间:2019/06/04
简介: 本课程是由火箭军总医院重症医学科的刘永飞主讲,主要讲述了重症患者抗菌药物的合理应用,从三个方面做了详尽的分析,第一讲述了抗菌药物分类及抗菌谱;第二讲述了抗菌药物合理应用原则;第三讲述了ICU常见耐药菌治疗方案。
主讲:刘永飞 课时:1 发布时间:2019/06/04
简介: 本期节目是火箭军总医院重症医学科刘永飞主讲的ICU抗真菌治疗,首先讲述了侵袭性真菌感染和侵袭性真菌病的定义,重症加强治疗病房患者是侵袭性真菌感染的高发人群,IFI日益成为导致ICU患者死亡的重要病因之一。接着讲述了常用抗真菌感染的常用药物,以及非中性粒细胞减少患者的念珠菌菌血症如何治疗等等。

主讲:刘永飞 课时:1 发布时间:2019/06/03
简介: PiCCO是一种简便、微创、高效费比的,对重症病人主要血液动力学和容量进行监护管理技术,同时对心脏和肺功能进行全面的评价。PiCCO参数也非常易于判断和理解、血管外肺水 床旁定量测量肺水肿PiCCO技术的优势。